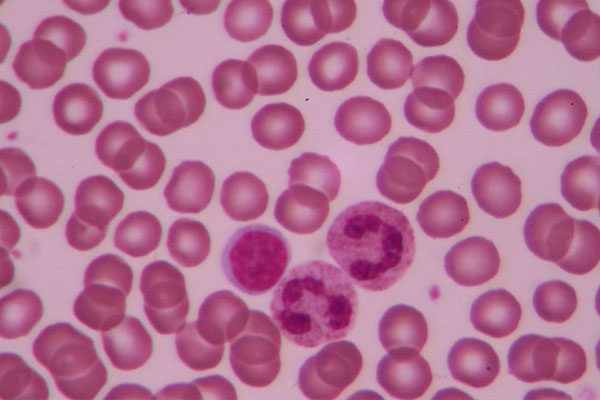
白细胞偏低的原因有哪些

-
高年龄女性做试管婴儿血糖值很重要,偏高偏低都会影响试管效果
怀孕是件不容易的事儿,通过试管婴儿怀孕这条路更艰难,试管婴儿的成功率不仅有限,其对妈妈身体的要求也是有限制的。而血糖的高低也会影响试管婴儿,血糖偏高或者过低,不..
2023-03-26 11:25 -

nt值偏低的话生女孩的几率大,那么nt值1.7mm是男孩女孩呢?
大宝是女孩,现在怀二胎了就希望是个男孩,都说现在生一儿一女的最幸福,我和老公也都想追一下潮流,毕竟儿女双全也是一桩美事不是吗。在得知怀孕的那一刻开始,我就已经在..
2023-05-28 08:40 -
7岁女孩子卵泡雌激素偏低
如果孩子体型比较匀称,则可以考虑是由于体内雌激素分泌过多引起,和垂体分泌功能紊乱有关。性早熟的孩子需要到医院进行详细的检查,7岁女孩子乳房发育之后到医院要做的是..
2023-06-14 07:40 -

尿酸碱度偏低危害大,想知道怎样改善看这里!
人体的尿液酸碱度是有一个正常值范围的,无论是偏高还是偏低都会对于身体健康有一定的影响,比如当酸碱度偏低时可能会有痛风、酸中毒等情况发生。水样ph酸碱度色别表尿酸碱..
2023-07-01 07:35 -
白细胞偏低的原因有哪些
导致白细胞偏低的原因是什么?到医院做检查,许多问题都需要通过血常规来反应,因此血常规是一项基础检查项目,白细胞的数量是一个必查指标,白细胞又称为白血球,在人体免..
2023-08-13 09:12 -

体温35.5正常吗 体温36度以下体温偏低是什么原因
平时我们听人骂人的时候总会说冷血动物,这是为何呢?因为人类是有温度的、有感情的,只有像蛇、鳄鱼之类冷血动物才对人冷漠无情。一般人体体温都是36度和37度左右,低于和..
2023-10-16 10:23 -

36岁女性amh值偏低用什么食补比较好?
年龄36周岁,近一年以来,月经每次差不多三天就结束了,只有第二天较多一点,但是能明显感觉我的月经在变少,于是我就去医院检查了一下性激素六项和AMH值,发现我的AMH值虽..
2024-03-24 19:25 -

amh值偏低还能不能做试管婴儿生孩子?
AMH值是评估女性生育能力的重要指标,一提到AMH,提到AMH低会引起不孕,其实这是一种错误的认知,AMH代表卵子的数目多与少,并不代表质量,所以即使AMH值低,仍然有可能自..
2024-04-25 09:25 -

什么是促黄体生成素_偏高偏低原因_怎么降解决办法
什么是促黄体生成素(lh)促黄体生成素(LH)主要是由垂体分泌的一种生殖激素,它存在于男性和女性中的作用都不相同,在男性中能帮助睾丸间质细胞分泌男性激素,在女性中能够..
2024-05-10 09:20 -

催乳激素是什么_偏高偏低|正常值|作用及治疗方法
催乳激素(PRL)简介催乳激素是一种由垂体前叶腺嗜酸细胞分泌的蛋白质激素,在属于孕前性激素六项检查项目中的一项;PRL含有近200个氨基酸并有少量的二硫键多肽,对于身体健..
2024-05-10 09:30 -

孕酮的偏高偏低对男性和女性都会带不小的影响。
对于很多男女性朋友来说,孕酮这个词是很陌生?其实它是人体性激素六项的主要之一,孕酮的偏高偏低对男性和女性都会带不小的影响。接下来带你了解什么是孕酮,为什么会带不..
2024-07-14 09:02 -

为什么现在得年轻人amh值普遍偏低?专家道出了真实的原因
为什么现在得年轻人amh值普遍偏低?专家道出了真实的原因:amh值是用来反应女性卵巢得储备数量情况,而amh值低有卵巢早衰得可能,但是是否真卵巢早衰还得结合性激素六项综..
2024-07-20 09:54 -

雌二醇偏低或偏高都对胎儿和母体有一定的影响,过低的危害有哪些?
女性在孕前检查过程中发现雌二醇偏低,就说明卵巢功能比较差。一、雌二醇偏低的话会直接影响卵泡发育,二、使子宫内膜变薄从而影响女性的怀孕情况。那么雌二醇偏低有哪些危..
2024-08-03 09:25 -

孕酮偏低与男女概率有关联吗?胎儿男女由什么决定的?
在科学研究中,人类基因和生理机能一直是令人着迷的课题之一。近年来,孕酮偏低与男女概率的关联引起了广泛关注。孕酮是一种重要的孕激素,它对妊娠的正常发展起着至关重要..
2024-08-30 11:49 -

AMH值偏低不可怕!伊能静AMH值不足0.1都能怀孕
只要做过不孕检查的患者,大多都会听到AMH,作为检测女性卵巢功能的重要指标,AMH偏低偏高都有着特别的意义,其中很多人都说AMH值偏低无法怀孕,其实并没有那么严重,像伊..
2024-11-10 09:44 -
有没有amh0.23偏低做试管还成功的案例?
准备做试管婴儿,在做试管前在医生指导下查了amh,值显示的是0.23,医生说有一些偏低,可能做试管的成功率不高,我想在这里问问你amh低做试管有成功的案例吗?amh低做试管..
2024-11-15 09:06 -
绝经后amh值0.47偏低做试管有希望吗?
绝经后做试管婴儿,在做试管前我的amh值只有0.47,医生说试管成功的概率只有50%,之前有过一次胎停和宫外孕史,老公精子质量也不好,现在也不知道该怎么办才好?想在这里问..
2024-11-15 09:20 -

怀孕偏低是否会影响男孩女孩的几率?为什么说怀孕偏低与胎儿男女有关?
怀孕时,性别是每个父母都非常关注的问题。有些人相信,如果胎儿位于子宫的左侧,它就是女孩;如果在右侧,则是男孩。还有一些人相信,如果母亲在受孕前吃得更多或在怀孕期..
2024-11-20 10:28 -

试管资讯:amh值偏低如何尽快怀孕?试管技术为你排忧解难
如果amh值低,怀孕的可能性会更低,但如果amh值没有降到零,还是有怀孕的机会的。建议越早怀孕越好,因为35岁以后,amh值会迅速降低,怀孕会更困难。那么amh值偏低如何尽快..
2025-01-20 09:34 -

囊胚移植前检查发现凝血酶原时间偏低影响试管吗?
我和老公结婚2年多,备孕一年都无果,去医院检查,结果显示多囊卵巢综合征,进行常规三次促排,两次都未孕,最后成功怀孕却生化了,最终选择最试管婴儿,但在移植前查出了..
2025-01-27 10:44
微信分享
扫描二维码分享到微信或朋友圈

